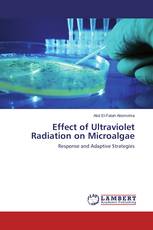
Effect of Ultraviolet Radiation on Microalgae

Sorry, Something is wrong with your request
Effectiveness of the Performance Based Financing Model in NGOs
Results, Experiences and Lessons from Zimbabwe
Eubert Vushoma, Ephraim Makoni - ISBN: 978-3-659-87923-4
River Bank Dwellers Perception – A Study Along Kunur River, WB, India
Amborish Das - ISBN: 978-3-659-87732-2
Net Capital Flow Variation as a Cause of Macroeconomic Instability
An investigation on Latin American economic development during the last two decades
Roberto Carline - ISBN: 978-3-659-87780-3
Adaptive assembly
Productivity improvement of assembly processes
Branislav Mičieta, Vladimíra Biňasová - ISBN: 978-3-659-87258-7
Controlling mixing and segregation in time periodic granular flows
Fascinating ideas and methods to control particle mixing and separation by using time-modulated and rate-based flows
Tathagata Bhattacharya - ISBN: 978-3-659-86574-9
Effect of Ultraviolet Radiation on Microalgae
Response and Adaptive Strategies
Abd El-Fatah Abomohra - ISBN: 978-3-659-87938-8
Роль человеческого капитала в инновационной экономике
Монография
Елена Ширинкина - ISBN: 978-3-659-87884-8
The Effect of Chronic Traumatic Experience on Palestinian Children
Mohamed Altawil - ISBN: 978-3-659-83458-5